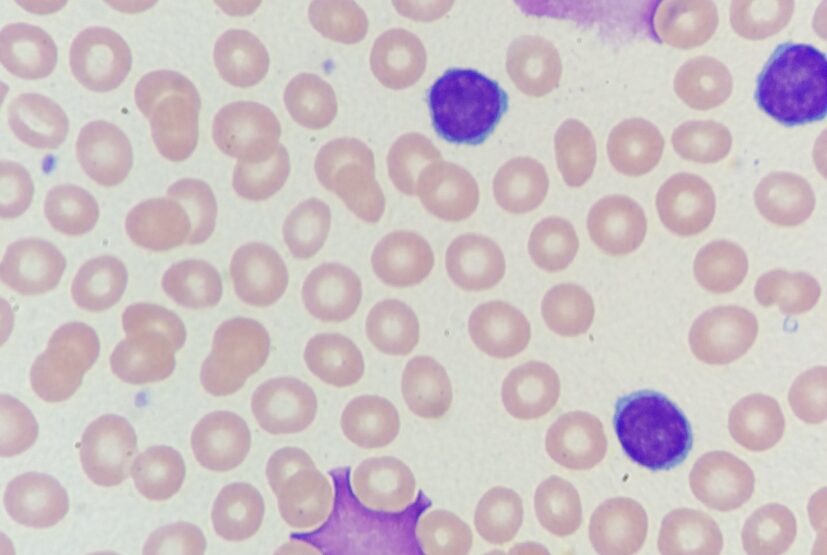

We use some essential cookies to make this website work.
We’d like to set additional cookies to understand how you use iwcll.org, remember your settings and improve our services.
We also use cookies set by other sites to help us deliver content from their services.